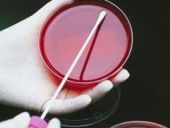
Bakteri direncini önleyen antibiyotik bulundu

SAĞLIK
 17 Ocak 2015 Cumartesi 14:00Anne babalar dikkat bu ürünlere dikkat!Çocuklar arasında oldukça sevilen renkli plastik bileziklerin kanserojen madde içerdiği tespit edildi.
17 Ocak 2015 Cumartesi 14:00Anne babalar dikkat bu ürünlere dikkat!Çocuklar arasında oldukça sevilen renkli plastik bileziklerin kanserojen madde içerdiği tespit edildi. Kitapla çocuk yetişir mi?Çocuk yetiştirmek için kitaplarda yer alan bilgiler yeterli olur mu? Konuyu uzmanlarına sorduk. Ağırlıklı görüş şöyle: “Bilmek ayrı uygulamak ayrı. Çocuk yetiştirmenin bir projeye dönüştürülmesi ve bir kariyer planı haline getirilmesini sakıncalı…”12 Ocak 2015 Pazartesi 04:00
Kitapla çocuk yetişir mi?Çocuk yetiştirmek için kitaplarda yer alan bilgiler yeterli olur mu? Konuyu uzmanlarına sorduk. Ağırlıklı görüş şöyle: “Bilmek ayrı uygulamak ayrı. Çocuk yetiştirmenin bir projeye dönüştürülmesi ve bir kariyer planı haline getirilmesini sakıncalı…”12 Ocak 2015 Pazartesi 04:00 Dünyanın acısını biz dindiriyoruzTürkiye, dünya sağlık sektörü açısından büyük önemi olan morfin ticaretinin yüzde 30’unu tek başına karşılıyor. Yasal haşhaş ekim alanlarının yüzde 47’si de Türkiye’de bulunuyor.10 Ocak 2015 Cumartesi 08:50
Dünyanın acısını biz dindiriyoruzTürkiye, dünya sağlık sektörü açısından büyük önemi olan morfin ticaretinin yüzde 30’unu tek başına karşılıyor. Yasal haşhaş ekim alanlarının yüzde 47’si de Türkiye’de bulunuyor.10 Ocak 2015 Cumartesi 08:50 Bakteri direncini önleyen antibiyotik bulunduAraştırma, "teixobactin" adlı antibiyotiğin ağır enfeksiyonları dirence yol açmadan yok edebildiğini gösterdi.08 Ocak 2015 Perşembe 11:12
Bakteri direncini önleyen antibiyotik bulunduAraştırma, "teixobactin" adlı antibiyotiğin ağır enfeksiyonları dirence yol açmadan yok edebildiğini gösterdi.08 Ocak 2015 Perşembe 11:12 Soğuk havalarda yüz felcine dikkatUzmanlar soğuk havada dikkat edilmezse yüz felci riskinin artacağını belirtti.08 Ocak 2015 Perşembe 10:49
Soğuk havalarda yüz felcine dikkatUzmanlar soğuk havada dikkat edilmezse yüz felci riskinin artacağını belirtti.08 Ocak 2015 Perşembe 10:49 Ebola’ya yeni umutHollanda'lı bir şirketin, Ebola virüsüne karşı yeni aşı geliştirdiği bildirildi.08 Ocak 2015 Perşembe 10:46
Ebola’ya yeni umutHollanda'lı bir şirketin, Ebola virüsüne karşı yeni aşı geliştirdiği bildirildi.08 Ocak 2015 Perşembe 10:46 Dikişsiz katarakt ameliyatıFakoemülsifikasyon yöntemiyle yapılan katarakt ameliyatlarında, küçük bir korneal kesiden tüm ameliyat gerçekleştiriliyor ve göze dikiş atılmıyor.06 Ocak 2015 Salı 09:54
Dikişsiz katarakt ameliyatıFakoemülsifikasyon yöntemiyle yapılan katarakt ameliyatlarında, küçük bir korneal kesiden tüm ameliyat gerçekleştiriliyor ve göze dikiş atılmıyor.06 Ocak 2015 Salı 09:54 Uzun yaşam DNA'sı balinalarda bulunduİngiliz bilim insanları uzun yaşamın sırlarına dair ipuçlarını Grönland balinalarının genlerinde buldu.06 Ocak 2015 Salı 09:18
Uzun yaşam DNA'sı balinalarda bulunduİngiliz bilim insanları uzun yaşamın sırlarına dair ipuçlarını Grönland balinalarının genlerinde buldu.06 Ocak 2015 Salı 09:18 KOAH'a karşı doğal koruma yöntemleriÖzellikle kış aylarında daha fazla alevlenen KOAH'tan doğal yöntemlerle korunma yöntemleri.06 Ocak 2015 Salı 09:07
KOAH'a karşı doğal koruma yöntemleriÖzellikle kış aylarında daha fazla alevlenen KOAH'tan doğal yöntemlerle korunma yöntemleri.06 Ocak 2015 Salı 09:07 Bu yiyecek 9 kişiyi öldürdüJaponya'da pirinçten yapılan hamur işi yapışkan yapısı nedeniyle bu yıl 9 kişinin yaşamını yitirmesine sebep oldu.06 Ocak 2015 Salı 04:31
Bu yiyecek 9 kişiyi öldürdüJaponya'da pirinçten yapılan hamur işi yapışkan yapısı nedeniyle bu yıl 9 kişinin yaşamını yitirmesine sebep oldu.06 Ocak 2015 Salı 04:31 Besin alerjisi olanlar dikkat!Yediğimiz bazı besinler yararının yanında alerjik reaksiyonlara da neden olabiliyor.05 Ocak 2015 Pazartesi 11:55
Besin alerjisi olanlar dikkat!Yediğimiz bazı besinler yararının yanında alerjik reaksiyonlara da neden olabiliyor.05 Ocak 2015 Pazartesi 11:55 28 bin hasta organ bekliyorTürkiye'de 28 binin üzerinde hasta, organ bağışıyla sağlığına kavuşmayı bekliyor.05 Ocak 2015 Pazartesi 11:30
28 bin hasta organ bekliyorTürkiye'de 28 binin üzerinde hasta, organ bağışıyla sağlığına kavuşmayı bekliyor.05 Ocak 2015 Pazartesi 11:30- Otizm hastalarının ilacı evcil hayvanlar05 Ocak 2015 Pazartesi 11:26
- BM'den ebola açıklaması05 Ocak 2015 Pazartesi 11:21
- En Kirli TOP 1005 Ocak 2015 Pazartesi 08:00
- Bu eşyaları kullananlar dikkat!04 Ocak 2015 Pazar 12:10
- Ebola virüsü yarasalardan mı geçti?03 Ocak 2015 Cumartesi 10:25
- Sağlık Bakanı solcu medyayı gerdi!03 Ocak 2015 Cumartesi 07:50
- Gelir testi yaptırdınız mı?02 Ocak 2015 Cuma 10:53
- Kaliteli bir uyku için bunu sakın yapmayın!02 Ocak 2015 Cuma 10:47
- Hacettepe Üniversitesinden büyük atak02 Ocak 2015 Cuma 10:42
- Göz yanıklarında bunu yapmalısınız02 Ocak 2015 Cuma 10:37
- Organları yeni yılda umut oldu01 Ocak 2015 Perşembe 09:52
- Sivilcelerden nasıl kurtulunur01 Ocak 2015 Perşembe 09:44
- Ortodonti tedavi süresi kısalıyor01 Ocak 2015 Perşembe 09:40
- Doktorlar bile inanamadı01 Ocak 2015 Perşembe 09:32
- Kelliğe kazayla çözüm bulundu31 Aralık 2014 Çarşamba 13:16
- Dünya'nın en yaşlı yapışık ikizleri31 Aralık 2014 Çarşamba 13:05
- Kırmızı et kansere neden oluyor31 Aralık 2014 Çarşamba 12:55
- Salça, zeytin ve meyve suyuna tuz ve şeker ayarı31 Aralık 2014 Çarşamba 08:00
- Sodalarda kanser riski30 Aralık 2014 Salı 12:55
- Beyninden 5 santimlik kurt çıktı30 Aralık 2014 Salı 09:31
SON HABERLER
- YENİ
- EN POPULER
- YILIN EN İYİLERİ
- YENİ
- EN POPULER
- YILIN EN İYİLERİ
EN ÇOK
SPOR SONUÇLARI
- 1. Beşiktaş245419
- 2. Galatasaray245215
- 3. Fenerbahçe245020
- 4. Bursaspor244117
- 5. İstanbul Başakşehir244015
- 6. Trabzonspor24408
- 16. Kayseri Erciyesspor2420-11
- 17. Karabükspor2418-11
- 18. Balıkesirspor2415-22
- Tümü
Sitemizdeki yazı, resim ve haberlerin her hakkı saklıdır. İzinsiz, kaynak gösterilmeden kullanılamaz.Haber Yazılımı: CM Bilişim























.jpg)


